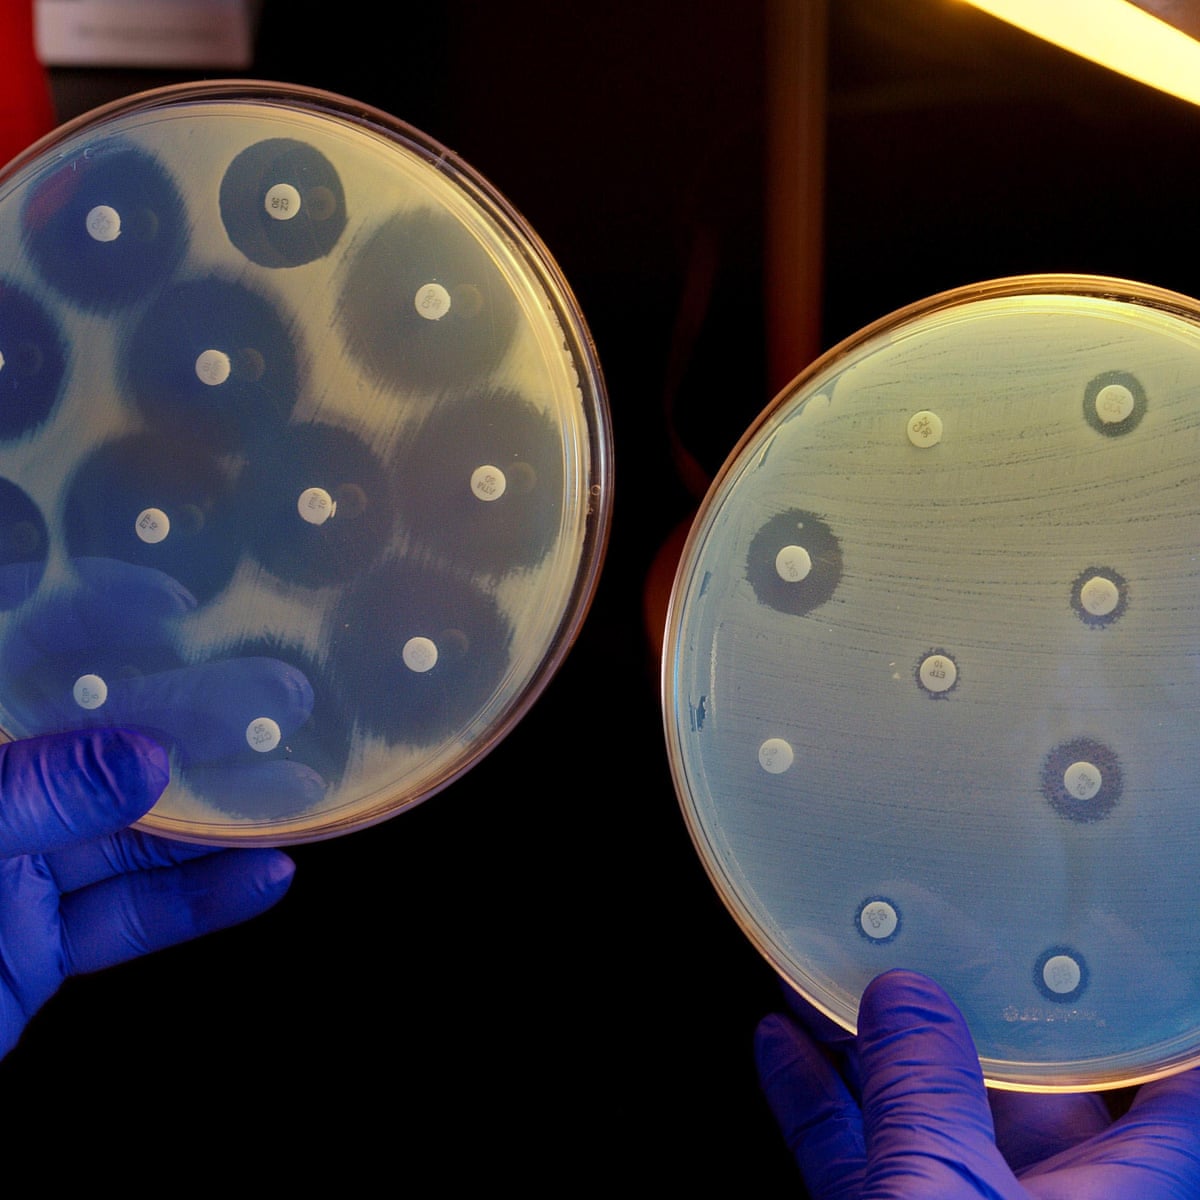

Edt Cpe

Considering Business Continuity In The World Of Covid 19 Free Live Cpe Calendar

Why Oasis Petroleum Callon Petroleum And Centennial Development All Jumped On July 10 The Motley Fool

Cpe Training Cpa Practice Advisor

Isc We Re Going Live In One Hour With Infoblox Join Our Members Only Discussion On Dns And How To Mitigate Threats Using Threat Intelligence And Analytics Nov 15 At 1 Pm
.jpg?ext=.jpg)
Cpe Webinar Salt Update Cohen Company

Copes Manual Edt Cpe Exm 7 95


Managing Complex Audits And Negotiating State And Local Tax Settlements Taxops

Signing Up For A Webinar

Getting Flexible With Ppp Free Live Cpe Calendar

Cisco Broadband Access Center Administrator S Guide Release 3 5 Cpe History And Troubleshooting Cisco Broadband Access Center For Telco And Wireless Cisco

Intro To Accountingsuite Multi Channel Inventory

Remote Working Is Way Forward To Grow For Cpa Firms Tax Accounting Firms
1

The Basics Of Business Valuation For M A Successful Acquisitions

Archived Webcasts With Cpe
My Cpe Infinite Banking Is A Powerful Tax Free Strategy Facebook

Cytopathic Effects Cpe Were Observed In Infected M Ricketti Lung R Download Scientific Diagram

Naic Summer Meeting Review 8 25

Virtual Smith Leonard Cpe Day 14th Annual

Dolce Vita By Christian Dior Edt Spray 3 4 Oz For Women Package Of 5 Stacksocial
My Cpe Home Facebook

Free Cpe Webcast How To Improve Efficiency As A Digital Firm May 28 Cpa Practice Advisor

Fedinsider Fedinsider Viewpoints On Government Management Part 3

Passkey Ea Review Free Cpe Announcements
Almost Untreatable Superbug Cpe Poses Serious Threat To Patients Doctors Warn Society The Guardian

Scanning Electron Microscopy Images Of Cpe A X1100 And Cpe 10 Edta Download Scientific Diagram

Metathinking A Cognitive Toolset For High Order Thinking 2 Cpe Hour Live Webinar 1 00 Pm Edt March 31 Toby Groves Ph D

Is It Time To Buy The Nyse S 3 Worst Performing Stocks Of So Far The Motley Fool

Gemtek Cpe Sequans

Free Cpe Webinar Up Your Cfo Game With Data Visualization Tools

Unconscious Bias 2 Cpe Hour Live Webinar 3 00 Pm Edt April 6 Toby Groves Ph D

Isc Cpe Opportunity Of The Week Join Our Live Webinar With Gigamon Discussing Using Inline Security Tools To Achieve Your Security Goals Thurs April 26 At 1 Pm Edt Earn

Accountability With A Small Staff And A Small Budget

Optimizing Financial Close Strategy Vaco

Cpe January 22 Options Begin Trading Nasdaq

Ledgent Cpe University Goes Virtual Ledgent Ledgent Finance Accounting

Webinars Archives Vaco

State Taxation Of Digital Goods And Services Cpe Taxops

Transforming Your Practice To High Performance Staffing Strategy
Isc Cpe Opportunity Of The Week Don T Miss Our Live Facebook

Smarter Social Security

Cpe Courses At No Cost For El Paso Texas Cpa S

Replace In Person Cpe Courses Programs With Online E Learning Etc
.jpg?ext=.jpg})
Cpe Webinar Salt Update Cohen Company
Iasa Inc Looking To Gain Cpe Credits You Can With Facebook

62nd Annual Meeting A Virtual Experience Cpe Certificate Survey

Cpe Live Review Course Rochester Ny Events The Association For Facilities Engineering

Pwc S Q2 Quarterly Accounting Webcast Free Live Cpe Calendar

Free Cpe Webcast How To Improve Efficiency As A Digital Firm May 28 Cpa Practice Advisor

New Events Landing Page

How Cpe Capital Escaped Australia S Succession Curse Private Equity International

Dealing With Irs Collections Division Part Ii

The Fgfoa Free Internet Based Webinar Series Presents Ppt Download

Isc Earn 1 Free Cpe We Will Be Discussing Developing A Culture Of Security At An Organization With Knowbe4 On July 19 At 1 Pm Edt Attend For Free And
Cpe 4485 In Tray By Cui Devices Buzzers And Indicators Future Electronics

Isc Looking To Discuss Challenges When Dealing With All Things Cloud Join Our Live Webinar Featuring A 18 Isc2congress Preview Cloud Security Tuesday July 24 At 1 Pm Edt

Transforming Your Practice To High Performance Staffing Strategy

The 4 Crude Oil Rally Wasn T The Only Thing Fueling Oil Stocks Today Cpe Hlx Sn Clmt Nasdaq

Free Cpe Webinar How To Sell Virtual Cfo Services

Get Off Nintendo Switch And Earn Some Cpe While You Re Working From Home Going Concern

Wed 9 Pm Edt On Wednesday S 11 13 Savannah Music Local And Sustainable From 9 10pm I Have My Second Hour Of Conversation With David Murray Pianist And Head Of The Piano Area At Georgia

Cpe Course Sections Schedule Weekly

Edt Cpe V2 Construire Les Emplois Du Temps Tuto N 4 Emplois Emploi Du Temps Emploi Cpe

Teaser Youtube

Archived Webcasts With Cpe

Metathinking A Cognitive Toolset For High Order Thinking 2 Cpe Hour Live Webinar 1 00 Pm Edt March 31 Toby Groves Ph D

Copes Self Scoring Booklet Edt Cpe Ahs 025 58 95

Callon Petroleum Co Cpe Stock Quote News Quantified

Data Analysis 101 Getting To The Heart Of Performance Data

Excel Formulas And Functions

Isc Cpe Opportunity Of The Week Don T Miss Our Live Discussion With Domaintools On The Changing Space Of Threat Intelligence And What Techniques You Can Employ To Stay Ahead Of

5 April Cpe Courses You Can T Miss Accounting And Tax News Insights Blog

Nacca Virtual Experience Cpe Certificate Survey
Auditforum Org Wp Content Uploads 07 7 30 23rd Biennial Final Agenda July 28 30 Pdf

Cfos Unsure About Letting Employees Earn Cpe During Work Hours Accounting Today

Covid 19 Effects On Credit Losses September Update Webinar Arcsys

Schellman Webinar Merging Swift Attestation With Cybersecurity Assessments

Archived Webcasts With Cpe
2

Cpa Cpe Cpe Webinars Encoursa

Mcgowenpro Accountant Engagement Letters Webinar 1 Free Cpe Thursday July 18 19 1pm Edt

Registration Closed The New Psychology Of Fraud 2 Cpe Hour Live Webinar 3 00 Pm Edt April 10 Toby Groves Ph D

Blx Group Pic Workshop Cpe Cle Credit Information

Cpa Cpe Cpe Webinars Encoursa

4 Tips To Secure Active Directory

Mid Year Tax Planning Considerations Webinar Sc H Group

Sharpening The Focus On Risk And Compliance Culture Webinar
Http Www Fgfoa Org Docs Default Source E Bulletin Fgfoa E Bulletin Impact Of Covid 19 On Financial Reporting Pdf Sfvrsn 1129dad5 4

Cpe Monitor Connecticut Pharmacists Association

Edt Cpe V3 Tutoriel En 5 Parties Youtube

Mindfully Tackling The Challenge Of The Coronavirus Acaus

Gaap Long Duration Targeted Improvements Five Key Updates For Insurers Free Live Cpe Calendar

Evm Practitioners Forum Day Two Virtual Project Controls Analyst Workshop October
Http Deloitte Wsj Com Cfo Files 12 06 Dfporh Pdf

Certent Join Emily Cervino Of Fidelity Barbara Mckenzie Of Bakermckenzie And Judy Ash Of Certentinc In This Special Cpe Event On 9 17 At 10 Am Pdt 1 Pm Edt As

Ethics In The Real World 2 Or 3 Cpe Hour Live Webinar 11 00 Am Edt April 7 Toby Groves Ph D
My Cpe Home Facebook
Isc Cpe Opportunity Of The Week Don T Miss Our Live Facebook
Protiviti Offers Cpe Education Series In Florida For Finance And Audit Professionals

Edt Cpe Un Outil Gratuit Cree Par Un Cpe Pour Les Cpe C P E Et Vie Scolaire